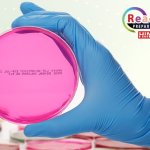

肌動蛋白抗體 | Beta Actin antibody貨號IR2-7 (IReal Biotechnology 艾鋭生技)

LDH乳酸脫氫酶檢測 (螢光) 試劑盒 | 貨號Abcam ab197004 (K314-500)

尿素酶活性檢測(Urease)檢測 | Urease Activity Assay Kit 貨號KTB3070

尿素酶活性分析試劑盒 |Urease Activity Assay Kit貨號ABCAM ab204697 (K378-100)

Hemocyanin-Keyhole Limpet (KLH), Native| 貨號abcam ab285712 (6288-25)

EpCAM 抗體 | EpCAM antibody (extracellular domain)貨號IR218-3 (IReal Biotechnology 艾鋭生技)

α-葡萄糖苷酶抑制劑篩選試劑盒 |α-Glucosidase Inhibitor Screening Kit貨號abcam ab284520 (K938-100)

組織因子/CD142胞外抗體 | Tissue Factor / CD142 extracellular antibody貨號IR295-1 (IReal Biotechnology 艾鋭生技)

登革病毒NS 1蛋白抗體 | Dengue virus NS 1 protein antibody貨號IRV005 (IReal Biotechnology 艾鋭生技)

蛋白酶活性檢測試劑盒 | Protease Activity Assay Kit Cayman貨號701410
